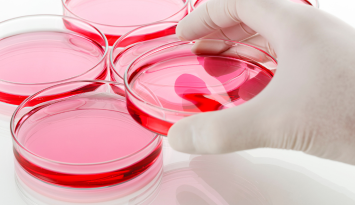
Small Molecules for Organoid Culture

Reagents supporting ES/iPS Cell Pluripotency and Differentiation Induction
ES/iPS cells possess both pluripotency, enabling differentiation into a wide variety of cell types, and self-renewal capacity, allowing them to proliferate while retaining their undifferentiated, pluripotent state.
Maintenance of pluripotency and differentiation induction into specific cell types are regulated by intracellular signaling pathways. Modulation of these pathways with small molecules enables efficient maintenance of pluripotency and differentiation induction. Growth factors such as cytokines exert similar effects. However, because growth factors are produced using Escherichia coli or cultured cells, there is a potential risk of contamination with endotoxin, animal-derived components, and lot-to-lot variability in performance.
In contrast, small molecules are generally synthesized chemically, eliminating the risk of contamination with endotoxin and animal-derived components. Furthermore, as they are manufactured through well-established synthetic processes, there is minimal lot-to-lot variation, enabling stable and reproducible culture results.
Fujifilm Wako provides a comprehensive range of reagents for ES/iPS cell culture, including media, sera, small molecules, and cytokines for the maintenance of pluripotency and differentiation induction.
Technical Resources and Webinars for ES/iPS Cell Research
Download a variety of free resources to support your ES/iPS cell research, including lists of small molecules used for maintenance of pluripotency and differentiation induction, cell differentiation maps, and informative white papers. You can also access free webinars featuring the latest research on ES/iPS cells. These resources are designed for both researchers developing the differentiation protocols of ES/iPS cell and those just starting research with ES/iPS cells.
■Resources
■Webinar
- Small Molecules for Basic Research
- CultureSure™ ProductsISO9001
- General Research Products ISO9001
- Small Molecules for Commercial Production
- GMP-Compliant Products ICH-Q7
- MF Products ISO9001
Differentiation Induction of iPS Cells into Neurons
Human brain tissue has limited capacity for regeneration compared with other organs. Consequently, current therapeutic approaches are often insufficient for treating neurodegenerative disorders and neurological injuries, including Parkinson’s disease, Huntington’s disease, schizophrenia, autism spectrum disorder, and epilepsy. Consequently, regenerative medicine strategies using stem cells, including iPS cells, to generate neurons have garnered considerable attention.
A commonly used approach for differentiation induction of iPS cells into neurons involves a two-step process:
1. From undifferentiated cells to neural progenitor cells
2. From neural progenitor cells to neurons
In this process, small molecules and cytokines are added at each stage to induce differentiation.

Differentiation Induction of iPS Cells into Cardiomyocytes
Heart failure and other cardiovascular diseases are currently treated with therapies such as heart transplantation and ventricular assist devices. Regenerative medicine strategies involving the transplantation of functional cardiomyocytes derived from stem cells are emerging as promising therapeutic alternatives. Advancing such regenerative approaches requires technologies that enable selective and efficient differentiation induction into cardiomyocytes, and intensive research in this area is ongoing.
A commonly used approach for differentiation induction of iPS cells into cardiomyocytes involves a two-step process:
1. From undifferentiated cells to mesoderm
2. From mesoderm to cardiomyocytes
In this process, small molecules and cytokines are added at each stage to induce differentiation.
Fujifilm Wako provides a wide range of products for differentiation induction of iPS cells into cardiomyocytes, including media, sera, extracellular matrix (ECM) proteins, small molecules, and cytokines.

Differentiation Induction of iPS Cells into Hepatocytes
Severe liver diseases, including viral hepatitis, alcoholic hepatitis, and hepatocellular carcinoma, have been challenging to treat with conventional therapies, particularly when it comes to effectively reversing hepatic fibrosis. To address this unmet need, regenerative approaches involving transplantation of hepatocytes derived from iPS cells have attracted attention as potential new treatment strategies. In drug discovery, iPS cell–derived hepatocytes enable cost-effective and accurate toxicity assessment, contributing to improved drug safety.
A commonly used approach for differentiation induction of iPS cells into hepatocytes involves a three-step process:
1. From undifferentiated cells to endoderm
2. From endoderm to hepatic progenitor cells
3. From hepatic progenitor cells to mature hepatocytes
In this process, small molecules and cytokines are added at each stage to induce differentiation.
Fujifilm Wako provides a comprehensive range of products for differentiation induction of iPS cells into hepatocytes, including media, sera, extracellular matrix (ECM) proteins, small molecules, and cytokines.

Small Molecules Optimized for Differentiation Induction of iPS Cells
This section highlights the advantages and key features of the small molecules offered by Fujifilm Wako. It provides useful information for researchers considering these products, helping them to make informed purchasing decisions.
Why Fujifilm Wako Products Are Chosen for Differentiation Induction of iPS Cells
-
Extensive Publication Record
Our products are widely cited in academic publications and research reports in Japan and internationally, reflecting their use across diverse research fields.
-
Comprehensive Product Portfolio
We offer small molecules for differentiation induction into a variety of cell types, including neurons, cardiomyocytes, and hepatocytes. We also provide related cell culture products, including media, sera, cell dissociation reagents, extracellular matrix (ECM) proteins, and cytokines.
-
Reliable Lead Times
We guarantee reliable delivery and offer flexible supply options to support customers’ research timelines.
-
Quality Assurance
Our products are manufactured under stringent quality control, including mycoplasma and endotoxin testing. We offer products ranging from research-grade reagents to GMP-compliant products, supporting applications from basic research to commercial manufacturing.

Product Comparison Table for Small Molecules for iPS Cells
Fujifilm Wako offers a wide range of products, from the CultureSure™ products for basic research in drug discovery and regenerative medicine to GMP-compliant products for commercial production.
| Product Portfolio | ICH-Q7 | ISO9001 | Sterility Testing |
Viable Count Testing |
No Animal- derived Ingredients Used |
Endotoxin Testing |
Mycoplasma Testing |
Residual Solvent Testing |
Powder / Liquid |
|---|---|---|---|---|---|---|---|---|---|
| CultureSure™ Series – Powder Products | - | ✓ | - | - | ✓ | ✓ | ✓ | - | Powder |
| CultureSure™ Series – Liquid Products | - | ✓ | ✓ | - | ✓ | ✓ | ✓ | - | Liquid |
| MF Products | - | ✓ | - | ✓ | ✓ | ✓ | ✓ | - | Powder |
| GMP-compliant Products | ✓ | ✓ | - | ✓ | ✓ | ✓ | ✓ | ✓ | Powder |
※Test items vary depending on the product, so please check the product specifications.
Small Molecules for Basic Research in Drug Discovery and Regenerative Medicine
CultureSure™ Products
CultureSure™ products are designed for basic research applications and are manufactured under ISO 9001–certified quality management system. In addition to standard testing in accordance with JIS(Japanese Industrial Standards) and related standards, they undergo rigorous microbiological testing, including endotoxin and mycoplasma testing, to ensure suitability for cell culture use. The CultureSure™ products is available in both powder and ready-to-use, filter-sterilized liquid formats.
General Research Products
These products have been developed for basic research applications and are manufactured under an ISO 9001–certified quality management system. They undergo testing in accordance with JIS and related standards, including assay and appearance specifications.
Small Molecules for Commercial Production of Regenerative Medicine Products
GMP-Compliant Products
These materials are designed for commercial production of regenerative medicine products and are manufactured in compliance with ICH-Q7 (GMP for APIs).
For details on Fujifilm Wako’s GMP compliance standards, see:≫About GMP-Compliant Small Molecules
Key Features
- GMP-compliant
- Process and analytical validation carried out
- No animal-derived ingredients are used in the raw materials
- Viable count, endotoxin, mycoplasma, and residual solvent testing
MF Products
These materials are designed for use in the commercial production of regenerative medicine products and are manufactured under ISO 9001–certified quality management system in facilities operated under internally defined quality standards.
Key Features
- Dedicated manufacturing facilities for cell culture additives to minimize contamination risk
- Process, analytical, and cleaning validation carried out
- No animal-derived ingredients are used in the raw materials
- Viable count, endotoxin, and mycoplasma testing
Small Molecules for Organoid Culture
Organoids partially recapitulate the structure and function of human organs on a smaller scale, enabling experiments to be conducted more quickly and cost-effectively than with native organs. They also address ethical concerns associated with animal use and allow experiments to be performed with higher precision compared with animal models. Organoids have been established for various tissues, including intestine, liver, and brain. Organoids generated from iPS cells are expected to find applications in regenerative medicine, including use as disease models, alternatives to organ transplantation, and for functional regeneration of organs.
Fujifilm Wako offers a comprehensive range of small molecules for organoid culture, including A-83-01, CHIR99021, SB431542, and Y-27632.
Product Line-up
For research use or further manufacturing use only. Not for use in diagnostic procedures.
Product content may differ from the actual image due to minor specification changes etc.
If the revision of product standards and packaging standards has been made, there is a case where the actual product specifications and images are different.
The prices are list prices in Japan.Please contact your local distributor for your retail price in your region.



